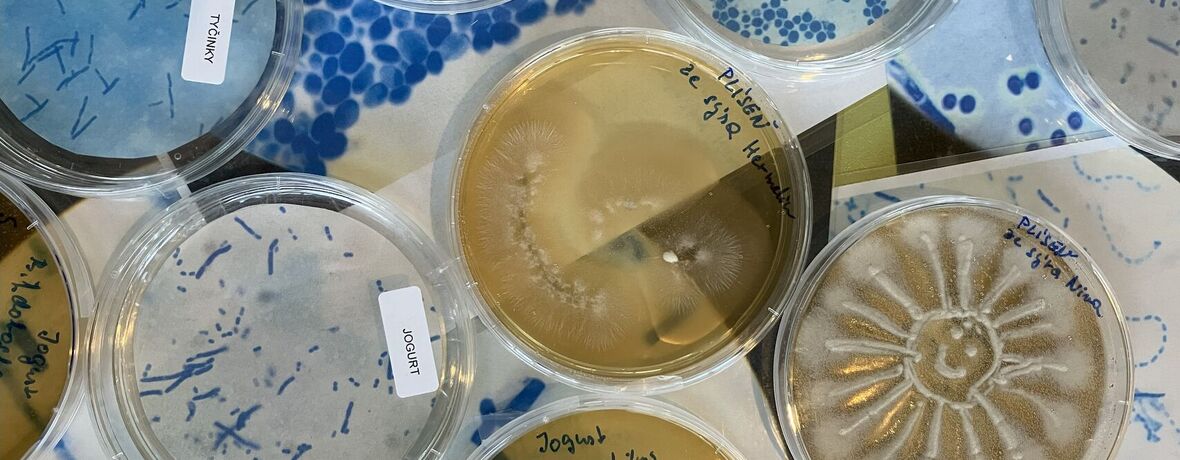
Neviditelní hrdinové kolem nás 11. a 12. 11. 2026

Společně si vysvětlíme, jaký význam mají mikroorganismy pro člověka: jak nám pomáhají při výrobě potravin, jak podporují zdraví a fungování mikrobiomu, ale také jak mohou způsobovat nemoci či kažení potravin.
Součástí programu je rozvoj praktických dovedností – žáci si vyzkoušejí pozorování vzorků pod mikroskopem a osvojí si základní hygienické zásady práce. Workshop zároveň představí potraviny vznikající působením mikroorganismů, například jogurt, kefír, sýry, chléb a další fermentované výrobky.
Program připravujeme ve spolupráci s Výzkumným ústavem mlékárenským a společností Milcom.